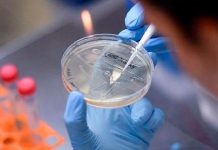

La situación epidemiológica en China vuelve a centrar las miradas, tres años después del inicio allí de la pandemia del coronavirus SARS-CoV-2. Tras relajar sus estrictas medidas de su política ‘Covid Cero’, el gigante asiático está enfrentándose a su primera gran ola, con récord de contagios y fallecimientos y con niveles de inmunidad que “no son los deseables” para los especialistas.
Tras anunciar que ya no exigirán hacer cuarentena a las personas que lleguen al país a partir del 8 de enero, lo cual animará a muchos chinos a viajar al extranjero tras casi tres años, países vecinos como Japón o Taiwán, pero también otros más alejados como EE.UU. o Italia han recuperado medidas de control.
El diario español ‘20 Minutos’ indica que Japón, Taiwán, Corea del Sur, India, Malasia y EE UU ya han anunciado que exigirán pruebas PCR a los viajeros procedentes de China. En la reunión del Comité de Seguridad Sanitaria la situación ante el incremento de casos Covid-19 en China tiene un “enfoque coordinado”.
En este encuentro se ha remarcado la importancia de seguir con la “senda de la coordinación europea” en políticas sanitarias y de continuar con una vigilancia activa, incluyendo la secuenciación del virus “como herramienta fundamental”.
La situación preocupa a otros países y también a los especialistas. El presidente de la Sociedad Española de Epidemiología, Óscar Zurriaga, afirma a 20minutos que “no se puede descartar en absoluto” que la transmisión en China dé lugar a una nueva variante que nos haga retroceder en términos de evolución epidemiológica.
Considera que la situación en el país asiático “nos debe preocupar a todos porque la información que tenemos es muy limitada. Así como al principio de la pandemia la ciencia china hizo un esfuerzo enorme para compartir datos y gracias a ellos obtuvimos PCR en muy poco tiempo, ahora las autoridades chinas no están respondiendo con la misma transparencia”.
“Para mí es más probable que aparezca un virus totalmente nuevo que que ómicron revierta hacia una situación más virulenta”, añadió.
Con información de Exitosa

![“Soy enfermera y me infecté por segunda vez de Covid-19. Ahora toda mi familia está contagiada” [Testimonio]](https://archivo.cutivalu.pe/wp-content/uploads/2020/05/testimonio-lady-1-e1590693047591-100x70.jpg)



